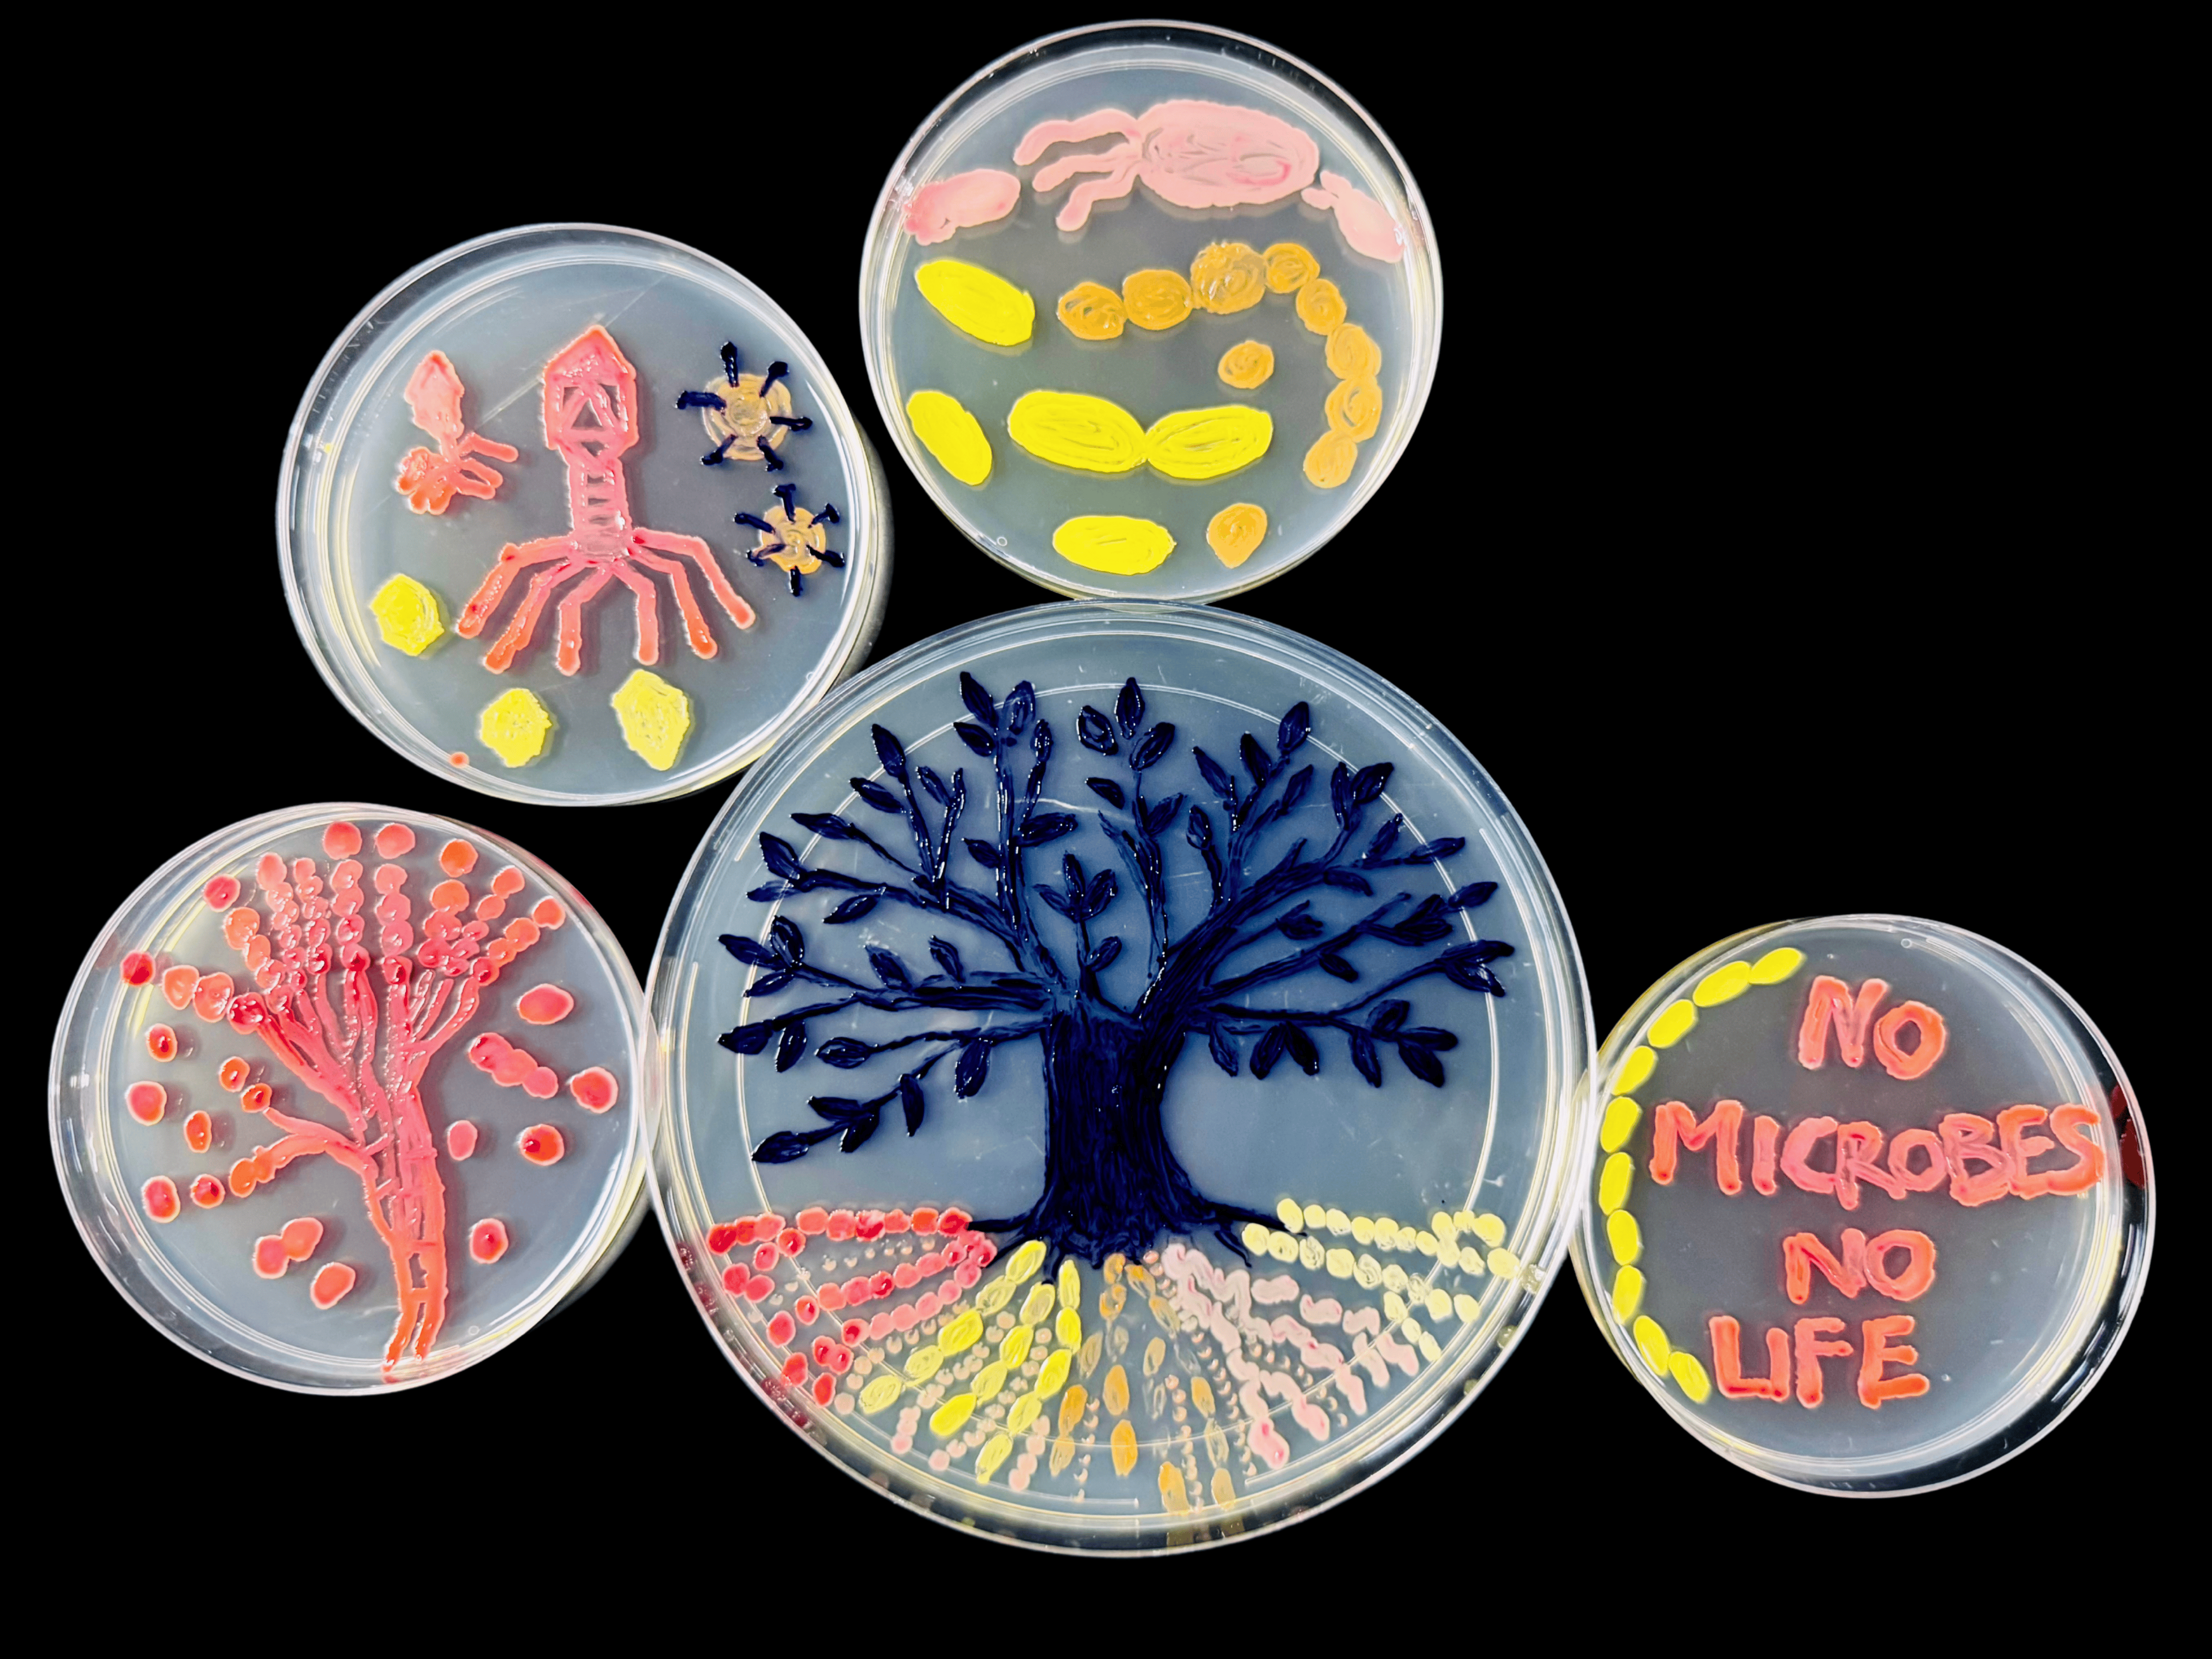
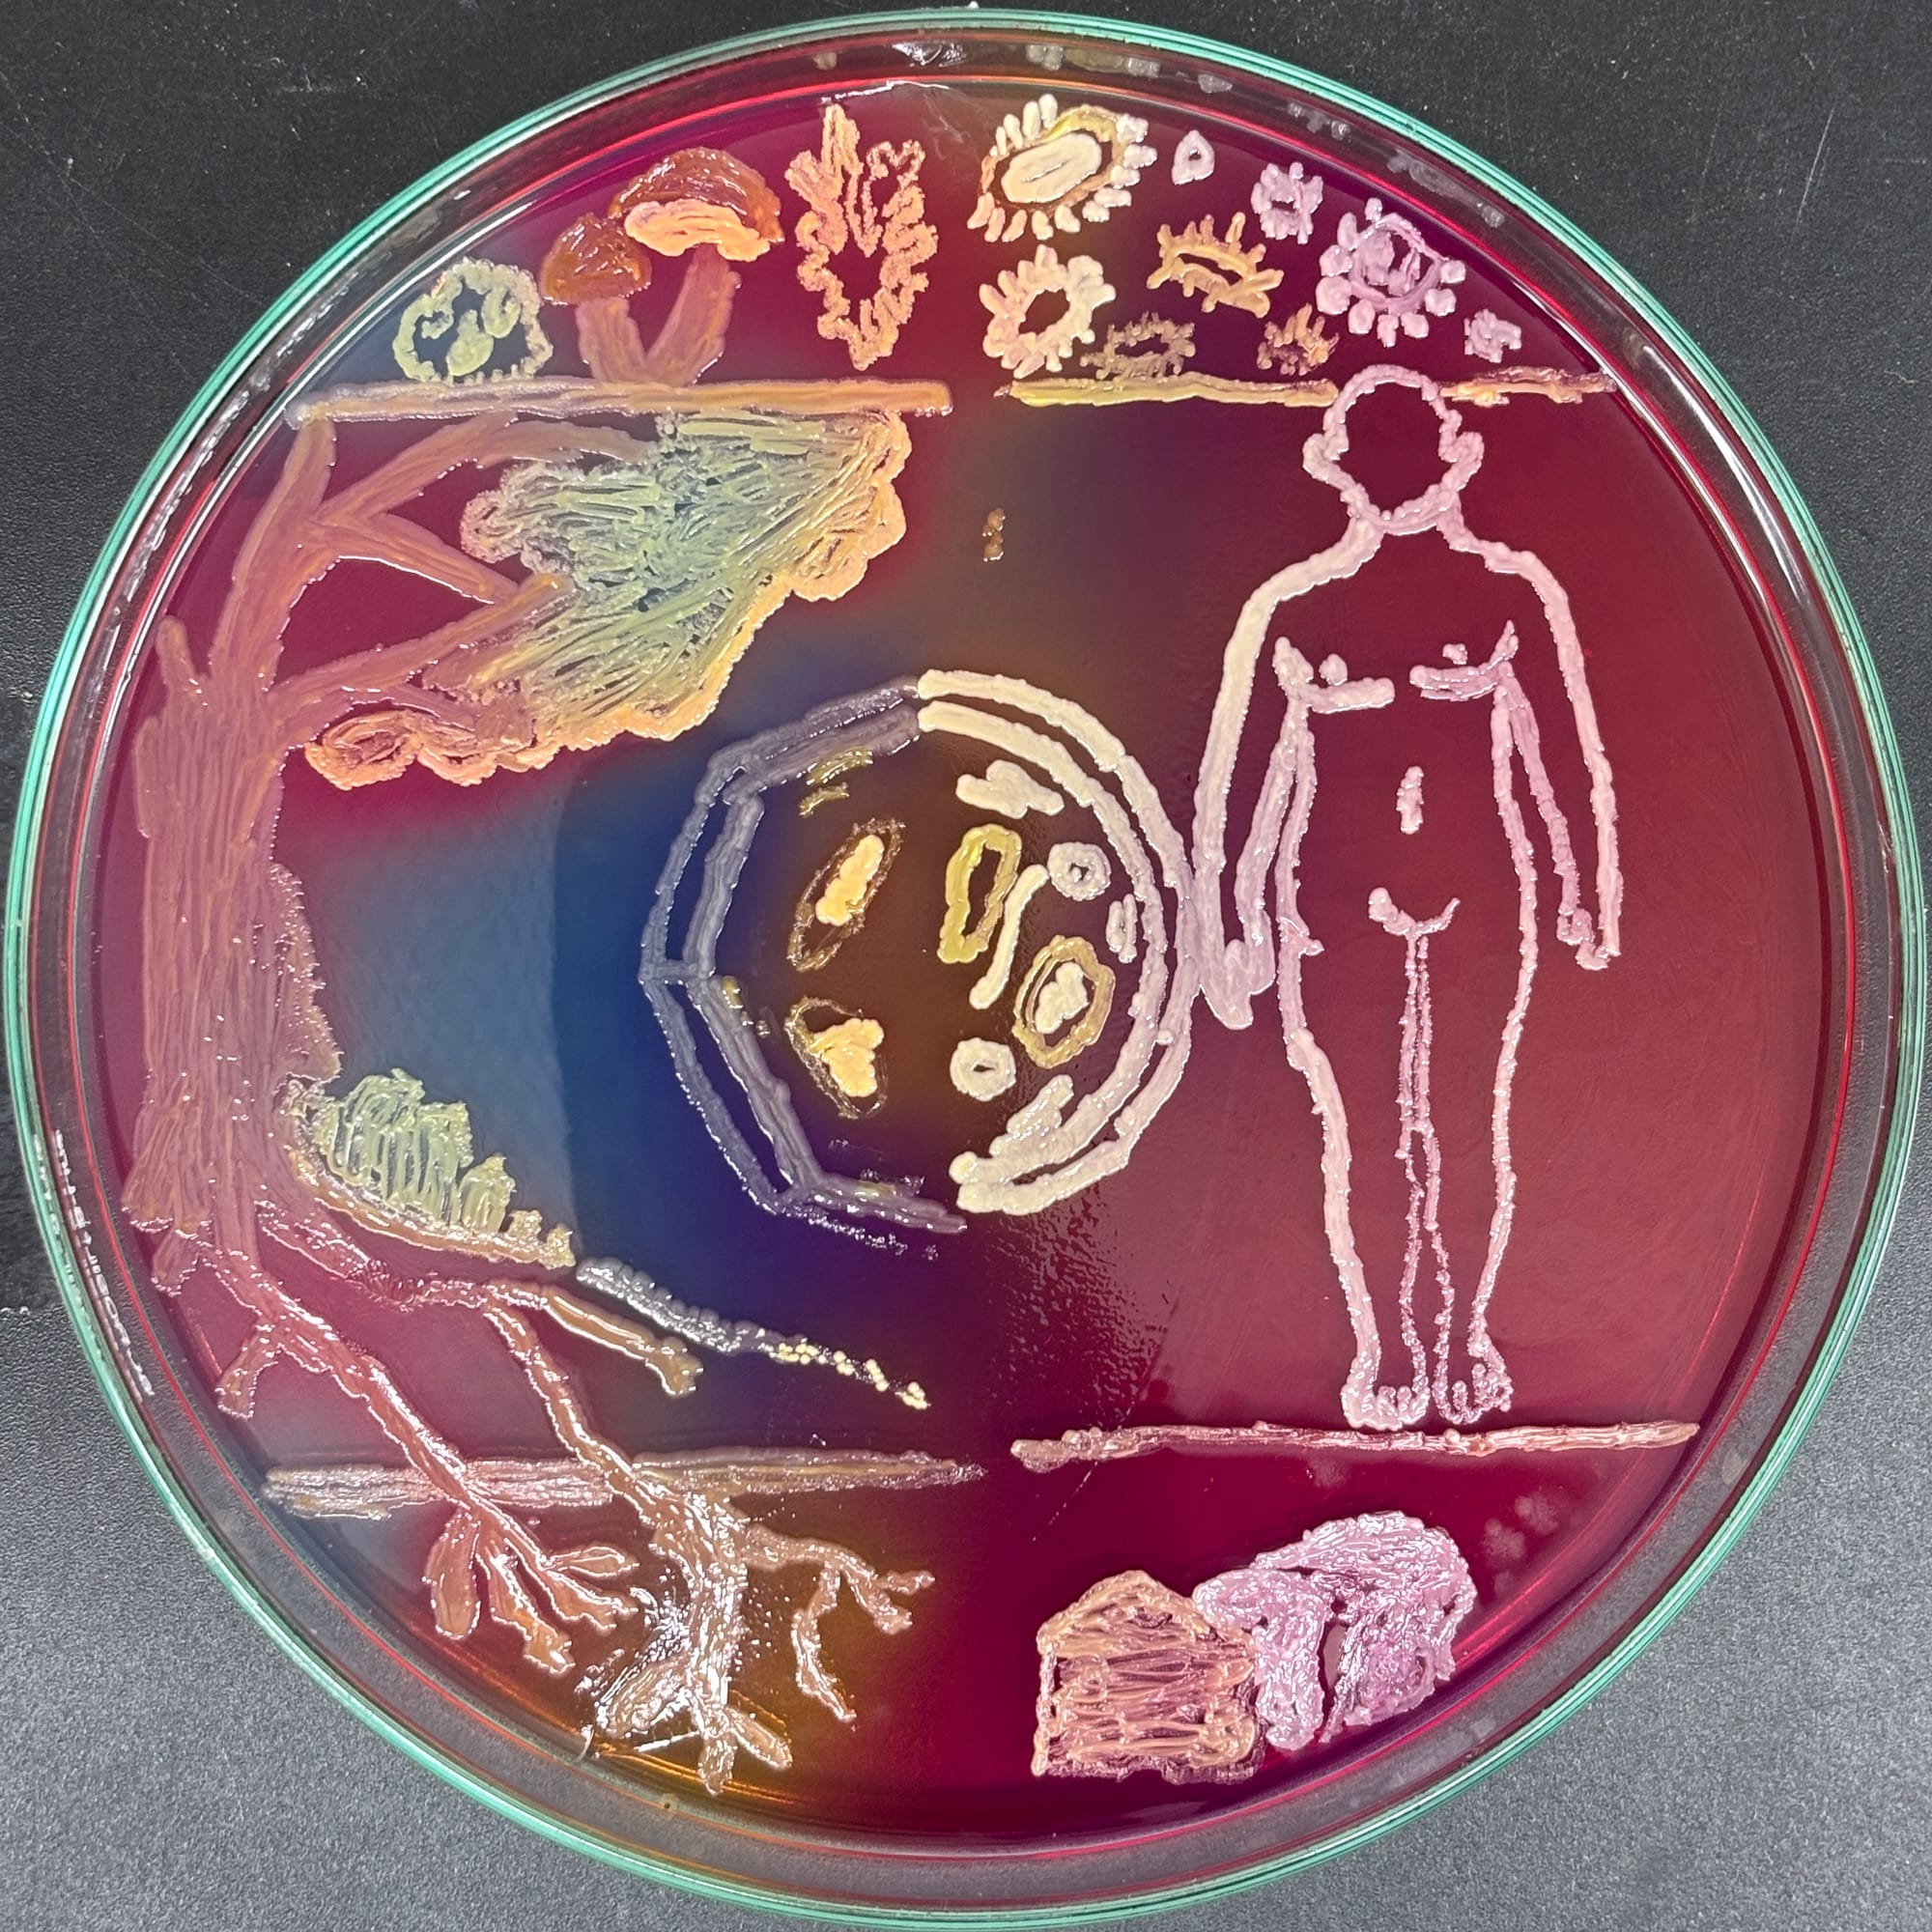
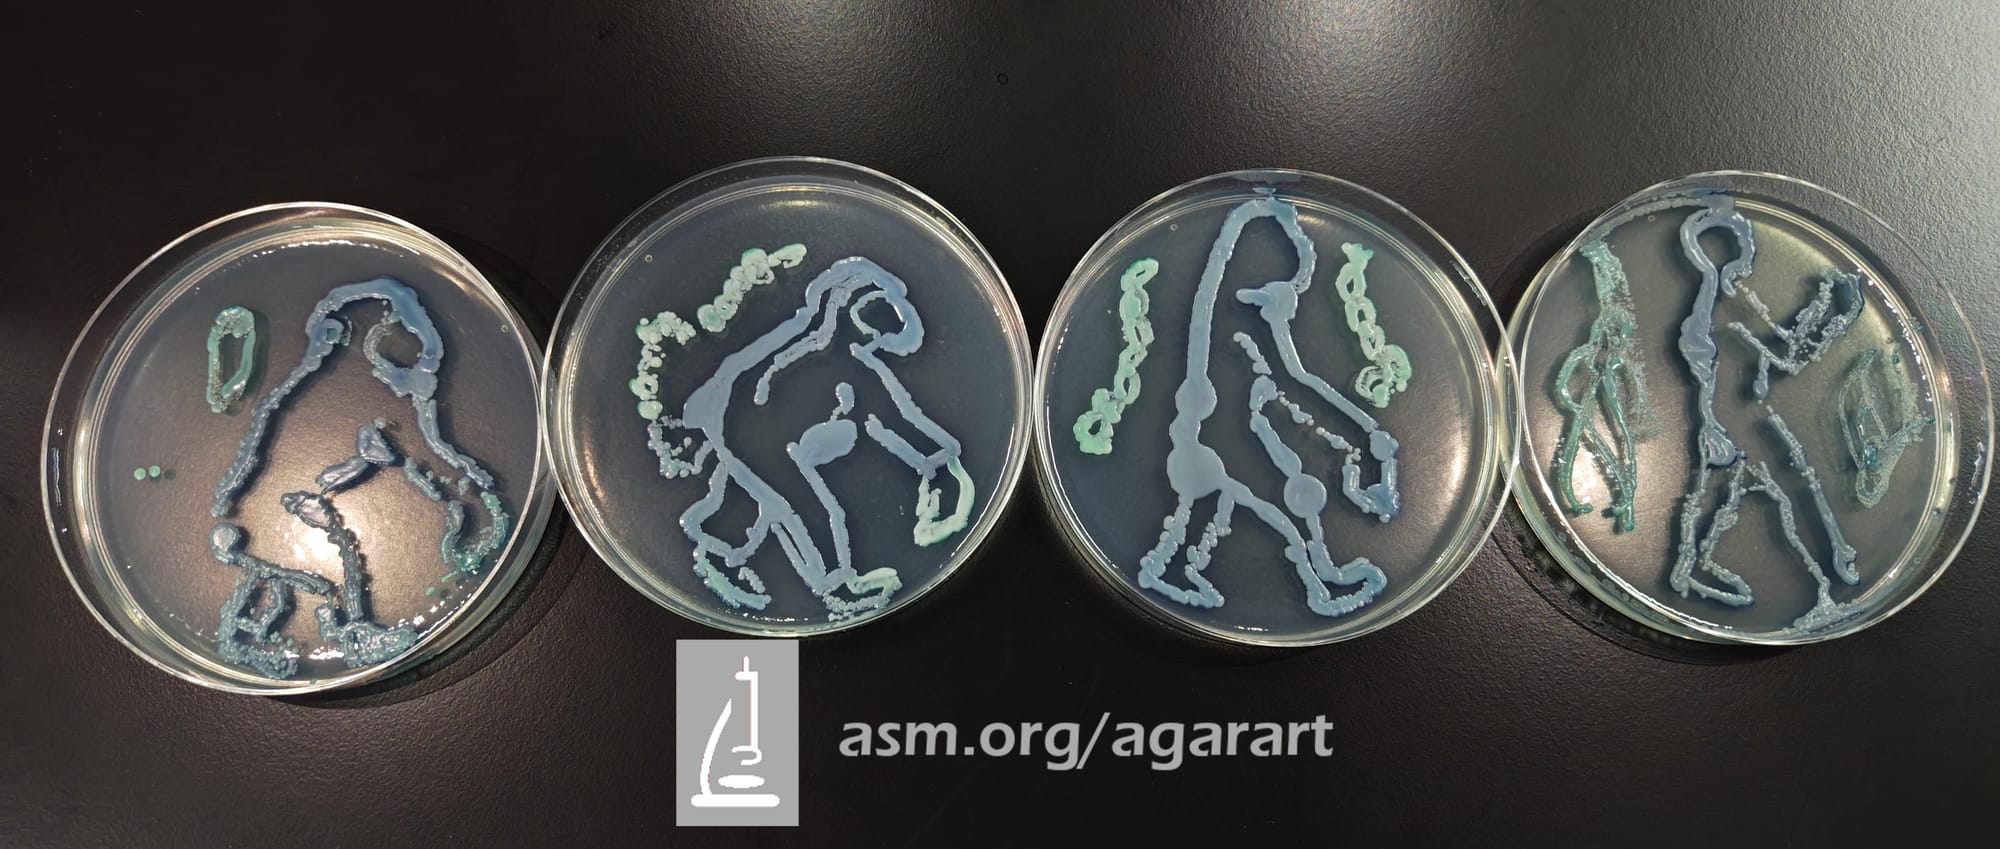

I worked in a biology lab for one summer in college, and I spent countless hours growing E. coli bacteria on agar-filled petri dishes for my experiments. It was a repetitive and mindless routine, yet, my graduate student supervisor had exacting standards. The plates and tools had to be sterilized thoroughly before the first bacterium moved in. He demanded for bacterial colonies that grow on the plates in a certain way — not in one massive blob but rather in islands like a chicken pox infection. Depending on how one smeared the bacterial seed culture onto fresh agar, one could get the desired growth pattern and proceed with the real science a few days later. Otherwise I had to toss out the whole batch and start over.
As a visual art, though, all these rules can be ignored. In agar art, agar is the canvas; microbes are the medium. Using different kinds of bacteria and getting creative with the strokes, one can even achieve a variety of colors and textures that make the resulting bacteria culture indistinguishable from a painting. Still, at the heart of it all, precision and technique are necessary for agar art as they are for agar science.
Agar art — probably conceived by a bored and rebellious microbiologist not too different from my undergraduate self, I'd like to imagine — isn't a new thing. In fact, it has grown into a quasi-competitive sport. Earlier this December, the American Society for Microbiology announced the winners of its 11th Agar Art Competition. This year's theme, "Microbes Make the World Go Round,” spurred 557 participants worldwide to imagine microbes doing their thing in various contexts, then use that very microbial life to illustrate their point for a macro-size audience. The results were vibrant, intricate, evocative, and above all, a whole lot of fun.
Would I have submitted something for this contest, had I caught wind of it while I was still in the lab, painting away in the same broad strokes plate after plate? Absolutely. Perhaps I could have convinced my supervisor to let loose a little, and throw in something of his own too.
(All images are the copyright of the American Society for Microbiology.)
In the professional category, submitted by contestants who work in a microbiology lab:





In the creator category, for those who meddle with microbes in an informal or irregular setting:

In the category of kids 13 and over:


In the category of kinds 12 and under:



